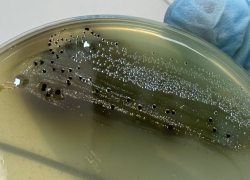
В Астраханской области готовили к продаже кур с очень опасными бактериями

Общество
-
В Астраханской области местами ожидают заморозки
Уже апрель, астраханцы успели почувствовать настоящее весеннее тепло — дневные температуры радовали солнцем и почти летним настроением. Однако погода решила ...
Читать полностью...
 Зампредседателя регионального правительства прибыл в город с рабочим визитом
Ключевые соцобъекты Ахтубинска прошли проверку Михаила Богомолова
вчера, 15:06
Зампредседателя регионального правительства прибыл в город с рабочим визитом
Ключевые соцобъекты Ахтубинска прошли проверку Михаила Богомолова
вчера, 15:06
 На 1,6 миллиона рублей за неделю
В Астрахани крупно оштрафовали нарушителей миграционного законодательства
вчера, 12:31
На 1,6 миллиона рублей за неделю
В Астрахани крупно оштрафовали нарушителей миграционного законодательства
вчера, 12:31
 Новая программа ориентирована на помощь детям погибших участников СВО
В Астраханской области создадут системную модель психологической помощи детям
вчера, 10:00
Новая программа ориентирована на помощь детям погибших участников СВО
В Астраханской области создадут системную модель психологической помощи детям
вчера, 10:00
 Мототехнику ввезли в Россию с нарушениями
Астраханские таможенники передали на нужды СВО более 140 мотоциклов
вчера, 09:17
Мототехнику ввезли в Россию с нарушениями
Астраханские таможенники передали на нужды СВО более 140 мотоциклов
вчера, 09:17
 Откосы кремля готовят к теплому времени года
Зелень Астраханского кремля обретает форму и красоту
вчера, 07:37
Откосы кремля готовят к теплому времени года
Зелень Астраханского кремля обретает форму и красоту
вчера, 07:37
 Придется ждать
В Астрахани завершили испытания на теплосетях, но горячую воду дали не всем
07.04.2026 21:34
Придется ждать
В Астрахани завершили испытания на теплосетях, но горячую воду дали не всем
07.04.2026 21:34
 Трудно не согласиться
Глава Астрахани резко высказался о ситуации с городскими водоемами: чего там только нет
07.04.2026 21:16
Трудно не согласиться
Глава Астрахани резко высказался о ситуации с городскими водоемами: чего там только нет
07.04.2026 21:16
 Формулировку изменили на увольнение в связи с утратой доверия
В Астрахани экс-полицейскому не дали уволиться по собственному желанию
07.04.2026 14:00
Формулировку изменили на увольнение в связи с утратой доверия
В Астрахани экс-полицейскому не дали уволиться по собственному желанию
07.04.2026 14:00
 На работу больше не надо
Двум умным собакам-полицейским из Астрахани ищут новую семью
07.04.2026 12:13
На работу больше не надо
Двум умным собакам-полицейским из Астрахани ищут новую семью
07.04.2026 12:13
 Ее общая стоимость превысила 19 миллионов рублей
Астраханским коммунальным и образовательным структурам передали новую технику
07.04.2026 11:40
Ее общая стоимость превысила 19 миллионов рублей
Астраханским коммунальным и образовательным структурам передали новую технику
07.04.2026 11:40
 Совещание состоялось в городской администрации под председательством главы Астрахани
В Астрахани обсудили изменения в миграционном законодательстве
07.04.2026 10:56
Совещание состоялось в городской администрации под председательством главы Астрахани
В Астрахани обсудили изменения в миграционном законодательстве
07.04.2026 10:56
 Будут и другие активности
12 апреля астраханцы отметят Пасху в кремле необычным квестом
07.04.2026 08:21
Будут и другие активности
12 апреля астраханцы отметят Пасху в кремле необычным квестом
07.04.2026 08:21
 Стоимость поездки на такси для многих очень дорогая
Жители трех сел потеряли прямое транспортное сообщение с Астраханью
07.04.2026 07:37
Стоимость поездки на такси для многих очень дорогая
Жители трех сел потеряли прямое транспортное сообщение с Астраханью
07.04.2026 07:37
 Что уже сделали
В астраханском кинотеатре "Октябрь" завершился очень важный этап работ
06.04.2026 20:24
Что уже сделали
В астраханском кинотеатре "Октябрь" завершился очень важный этап работ
06.04.2026 20:24
 Животному требовалась срочная медпомощь
Астраханские спасатели эвакуировали из задымленного дома 25 человек и кошку
06.04.2026 11:40
Животному требовалась срочная медпомощь
Астраханские спасатели эвакуировали из задымленного дома 25 человек и кошку
06.04.2026 11:40
 И обсудили основные задачи
В Астрахани проверили условия работы линейного отдела полиции
06.04.2026 10:48
И обсудили основные задачи
В Астрахани проверили условия работы линейного отдела полиции
06.04.2026 10:48
 Состоялась встреча начальника УТ МВД и областного правительства
В Астрахани положительно отметили работу линейного отдела МВД на транспорте
06.04.2026 08:22
Состоялась встреча начальника УТ МВД и областного правительства
В Астрахани положительно отметили работу линейного отдела МВД на транспорте
06.04.2026 08:22
 В СМИ появляются сообщения о возможности десятилетнего обучения
Минпросвещения: изменится ли система образования в школах Астраханской области
06.04.2026 07:37
В СМИ появляются сообщения о возможности десятилетнего обучения
Минпросвещения: изменится ли система образования в школах Астраханской области
06.04.2026 07:37
 Как и насколько
Цены на главные продукты в Астраханской области продолжают меняться
05.04.2026 13:09
Как и насколько
Цены на главные продукты в Астраханской области продолжают меняться
05.04.2026 13:09
 И увеличат площадь под батат
В Астраханской области откроют ферму по переработке верблюжьего молока
05.04.2026 06:45
И увеличат площадь под батат
В Астраханской области откроют ферму по переработке верблюжьего молока
05.04.2026 06:45
 В центре внимания — дворовая среда
Детство не в телефоне: в Астрахани сдали первые дома жилого квартала без машин
03.04.2026 09:39
В центре внимания — дворовая среда
Детство не в телефоне: в Астрахани сдали первые дома жилого квартала без машин
03.04.2026 09:39
Партия товара - 400 килограммов
В Астраханской области готовили к продаже кур с очень опасными бактериями
03.04.2026 09:06
Партия товара - 400 килограммов
В Астраханской области готовили к продаже кур с очень опасными бактериями
03.04.2026 09:06
 Ему окажут господдержку
В Астрахани хлебозавод делает то, что ни одно предприятие страны: что это
02.04.2026 08:19
Ему окажут господдержку
В Астрахани хлебозавод делает то, что ни одно предприятие страны: что это
02.04.2026 08:19
 Сколько он продлится
С сегодняшнего дня в Астраханской области запретили ловить еще одного речного обитателя
01.04.2026 19:43
Сколько он продлится
С сегодняшнего дня в Астраханской области запретили ловить еще одного речного обитателя
01.04.2026 19:43
 А из Узбекистана ввезли зелень
Астраханская область отправила самолетом в Гонконг много рыбы
01.04.2026 10:30
А из Узбекистана ввезли зелень
Астраханская область отправила самолетом в Гонконг много рыбы
01.04.2026 10:30
 Для быстрорастущего населения
Под Астраханью скоро начнут строительство современной поликлиники
01.04.2026 05:40
Для быстрорастущего населения
Под Астраханью скоро начнут строительство современной поликлиники
01.04.2026 05:40
 Об этом сообщил губернатор Игорь Бабушкин в своих социальных сетях
Паводок в Астраханской области ожидается выше уровня прошлых лет
31.03.2026 13:40
Об этом сообщил губернатор Игорь Бабушкин в своих социальных сетях
Паводок в Астраханской области ожидается выше уровня прошлых лет
31.03.2026 13:40
 Сбор участников у Центра зимних видов спорта
В Астраханской области состоится Всероссийская акция «10 000 шагов к жизни»
30.03.2026 14:50
Сбор участников у Центра зимних видов спорта
В Астраханской области состоится Всероссийская акция «10 000 шагов к жизни»
30.03.2026 14:50
 Возбуждено 6237 дел об административных правонарушениях
Из незаконного оборота в Астраханской области изъято около 250 тонн водных биоресурсов
30.03.2026 09:48
Возбуждено 6237 дел об административных правонарушениях
Из незаконного оборота в Астраханской области изъято около 250 тонн водных биоресурсов
30.03.2026 09:48
 Конкурс проводится 15 лет
Мисс-Этно 2026 стала представительница казахской культуры
30.03.2026 09:14
Конкурс проводится 15 лет
Мисс-Этно 2026 стала представительница казахской культуры
30.03.2026 09:14
 Не спешите выезжать на весенние магистрали
«Автодор» рекомендовал астраханским мотоциклистам тщательно готовиться к мотосезону
30.03.2026 08:55
Не спешите выезжать на весенние магистрали
«Автодор» рекомендовал астраханским мотоциклистам тщательно готовиться к мотосезону
30.03.2026 08:55
 Погода радует астраханцев последние несколько дней
Астраханцев ожидает теплая, но дождливая неделя
29.03.2026 18:03
Погода радует астраханцев последние несколько дней
Астраханцев ожидает теплая, но дождливая неделя
29.03.2026 18:03
 Кажется, похолодания больше не ждем
В Астрахани назначили новую дату окончания отопительного сезона
28.03.2026 09:51
Кажется, похолодания больше не ждем
В Астрахани назначили новую дату окончания отопительного сезона
28.03.2026 09:51
 Астраханская полиция доложила о криминальной обстановке в регионе
Начальник астраханской полиции: раскрываемость преступлений составила 57,6%
28.03.2026 09:30
Астраханская полиция доложила о криминальной обстановке в регионе
Начальник астраханской полиции: раскрываемость преступлений составила 57,6%
28.03.2026 09:30
 По случаю Дня образования Федеральной службы войск национальной гвардии России
Сотрудники и военнослужащие астраханской Росгвардии получили награды губернатора
28.03.2026 08:30
По случаю Дня образования Федеральной службы войск национальной гвардии России
Сотрудники и военнослужащие астраханской Росгвардии получили награды губернатора
28.03.2026 08:30
 Выявлено 13 нарушителей
Под Астраханью в тепличном комплексе разоблачили работников-нелегалов
27.03.2026 15:38
Выявлено 13 нарушителей
Под Астраханью в тепличном комплексе разоблачили работников-нелегалов
27.03.2026 15:38
 Победитель отправится на международные соревнования в Южную Корею
Астраханский «ЛОТОС ФЕСТ» собрал более 4000 участников
27.03.2026 12:30
Победитель отправится на международные соревнования в Южную Корею
Астраханский «ЛОТОС ФЕСТ» собрал более 4000 участников
27.03.2026 12:30
 Вместе с недвижимостью и автомобилем
50 миллионов рублей бывшего астраханского пристава обратят в доход государства
27.03.2026 11:44
Вместе с недвижимостью и автомобилем
50 миллионов рублей бывшего астраханского пристава обратят в доход государства
27.03.2026 11:44
 Температурный режим был нарушен в 56 МКД
Астраханцам сделали перерасчет за плохое отопление на пять миллионов рублей
27.03.2026 10:56
Температурный режим был нарушен в 56 МКД
Астраханцам сделали перерасчет за плохое отопление на пять миллионов рублей
27.03.2026 10:56
 К сожалению, одна женщина погибла
Астраханские огнеборцы боролись с огнем в девятиэтажке и эвакуировали 14 человек
26.03.2026 14:00
К сожалению, одна женщина погибла
Астраханские огнеборцы боролись с огнем в девятиэтажке и эвакуировали 14 человек
26.03.2026 14:00
 За год не было ни одного случая первичной заболеваемости наркоманией
У Астраханской области минимальный уровень напряженности наркоситуации
26.03.2026 12:24
За год не было ни одного случая первичной заболеваемости наркоманией
У Астраханской области минимальный уровень напряженности наркоситуации
26.03.2026 12:24
 В УМВД прокомментировали недостоверную информацию
Астраханцев напугали фейком о праве полиции проверять телефоны на запрещенку
26.03.2026 10:00
В УМВД прокомментировали недостоверную информацию
Астраханцев напугали фейком о праве полиции проверять телефоны на запрещенку
26.03.2026 10:00
 Что же нам прогнозируют синоптики?
В Астрахани заморозки отодвинули завершение отопительного сезона
26.03.2026 07:36
Что же нам прогнозируют синоптики?
В Астрахани заморозки отодвинули завершение отопительного сезона
26.03.2026 07:36
 Он же поручил решить их проблему с нехваткой швейной техники
Игорь Бабушкин наградил астраханских волонтеров за поднятие боевого духа солдат
25.03.2026 13:15
Он же поручил решить их проблему с нехваткой швейной техники
Игорь Бабушкин наградил астраханских волонтеров за поднятие боевого духа солдат
25.03.2026 13:15
 «Есть опасения, что воду начнут сбрасывать раньше нужного нам периода»
Астраханский губернатор обсудил предстоящий паводок с рыбоводами
25.03.2026 11:44
«Есть опасения, что воду начнут сбрасывать раньше нужного нам периода»
Астраханский губернатор обсудил предстоящий паводок с рыбоводами
25.03.2026 11:44
 В группе риска ребята 7-9 классов
В Астрахани обсудили профилактику наркомании среди школьников
25.03.2026 10:00
В группе риска ребята 7-9 классов
В Астрахани обсудили профилактику наркомании среди школьников
25.03.2026 10:00
 В рамках проекта службы занятости по маршрутизации молодежи
В Астраханской области студентам с риском нетрудоустройства помогут найти работу
24.03.2026 15:34
В рамках проекта службы занятости по маршрутизации молодежи
В Астраханской области студентам с риском нетрудоустройства помогут найти работу
24.03.2026 15:34
 Они занимались этим на улице Адмиралтейской
Астраханским коммунальщикам поручили отмыть фасады городских домов
24.03.2026 13:05
Они занимались этим на улице Адмиралтейской
Астраханским коммунальщикам поручили отмыть фасады городских домов
24.03.2026 13:05
 60 иностранцам запретили въезд в Россию
В астраханских общежитиях и точках общепита выявили 206 миграционных нарушений
24.03.2026 12:20
60 иностранцам запретили въезд в Россию
В астраханских общежитиях и точках общепита выявили 206 миграционных нарушений
24.03.2026 12:20
 С 23 марта в регионе вступили в силу жесткие запреты
В Астраханской области объявили пожароопасный сезон: штрафы за нарушение кусаются
24.03.2026 10:56
С 23 марта в регионе вступили в силу жесткие запреты
В Астраханской области объявили пожароопасный сезон: штрафы за нарушение кусаются
24.03.2026 10:56
 В регионе определяют объекты для благоустройства в 2027 году
Жители Астрахани, Знаменска и Лиманского округа предложили идеи благоустройства
24.03.2026 10:00
В регионе определяют объекты для благоустройства в 2027 году
Жители Астрахани, Знаменска и Лиманского округа предложили идеи благоустройства
24.03.2026 10:00
 Кажется, он оказался там случайно
На территорию охраняемого объекта проник астраханец в федеральном розыске
24.03.2026 09:42
Кажется, он оказался там случайно
На территорию охраняемого объекта проник астраханец в федеральном розыске
24.03.2026 09:42
 Власти напомнили, для чего это делается
Астраханцам вынужденно замедляют скорость мобильного интернета
24.03.2026 08:22
Власти напомнили, для чего это делается
Астраханцам вынужденно замедляют скорость мобильного интернета
24.03.2026 08:22
 Система перестанет страдать от нагрузки, вызванной весом автомобилей
В центре Астрахани канализационные трубы перемещают под пешеходную зону
24.03.2026 07:35
Система перестанет страдать от нагрузки, вызванной весом автомобилей
В центре Астрахани канализационные трубы перемещают под пешеходную зону
24.03.2026 07:35
 Проявляйте бдительность!
Испытания трубопроводов тепловых сетей в Астрахани перенесли на апрель
23.03.2026 14:03
Проявляйте бдительность!
Испытания трубопроводов тепловых сетей в Астрахани перенесли на апрель
23.03.2026 14:03
 Только импортные хрусталики!
Лечение катаракты по полису ОМС для жителей Астраханской области
23.03.2026 10:00
Только импортные хрусталики!
Лечение катаракты по полису ОМС для жителей Астраханской области
23.03.2026 10:00
 Ребята сняли ролик про эвакуацию
Астраханский инклюзивный коллектив «Зазеркалье» победил на всероссийском историческом конкурсе
23.03.2026 09:30
Ребята сняли ролик про эвакуацию
Астраханский инклюзивный коллектив «Зазеркалье» победил на всероссийском историческом конкурсе
23.03.2026 09:30
 Готовьте обращения!
Денис Афанасьев проведет Прямую связь с Правительством Астраханской области
22.03.2026 22:37
Готовьте обращения!
Денис Афанасьев проведет Прямую связь с Правительством Астраханской области
22.03.2026 22:37
 Помощь оказывается в виде льгот, преференций, в денежной форме
В Астраханской области разработали больше 80 мер поддержки участников СВО
21.03.2026 10:30
Помощь оказывается в виде льгот, преференций, в денежной форме
В Астраханской области разработали больше 80 мер поддержки участников СВО
21.03.2026 10:30
 Заметив росгвардейцев, мужчина попытался сбежать
Названивал и караулил у дома: астраханца задержали за преследование девочки
21.03.2026 08:30
Заметив росгвардейцев, мужчина попытался сбежать
Названивал и караулил у дома: астраханца задержали за преследование девочки
21.03.2026 08:30
 Проект поддерживает дизайнеров и моделей – начинающих и профессиональных
Астраханок пригласили стать участницами фэшн шоу «Подиум Юга»
20.03.2026 14:46
Проект поддерживает дизайнеров и моделей – начинающих и профессиональных
Астраханок пригласили стать участницами фэшн шоу «Подиум Юга»
20.03.2026 14:46
 На портале «Работа России» доступны 20 программ
Астраханцы подали 243 заявки на бесплатное обучение востребованным профессиям
20.03.2026 14:01
На портале «Работа России» доступны 20 программ
Астраханцы подали 243 заявки на бесплатное обучение востребованным профессиям
20.03.2026 14:01
 Чем выше доход, тем чаще работают по профилю
Только 43% опрошенных астраханцев работают по специальности
20.03.2026 11:00
Чем выше доход, тем чаще работают по профилю
Только 43% опрошенных астраханцев работают по специальности
20.03.2026 11:00
 Местная жительница защитила свою честь и достоинство
Астраханка компенсирует моральный вред жертве своих резких слов
20.03.2026 10:12
Местная жительница защитила свою честь и достоинство
Астраханка компенсирует моральный вред жертве своих резких слов
20.03.2026 10:12
 В порядок приведут объездную дорогу, школы, детскую площадку
Астраханцам сообщили планы по благоустройству и ремонту на приеме у губернатора
20.03.2026 08:27
В порядок приведут объездную дорогу, школы, детскую площадку
Астраханцам сообщили планы по благоустройству и ремонту на приеме у губернатора
20.03.2026 08:27
 До окончания мероприятий в честь Ураза-байрама
20 марта в Астрахани действуют ограничения на парковку для всех автомобилистов
20.03.2026 07:32
До окончания мероприятий в честь Ураза-байрама
20 марта в Астрахани действуют ограничения на парковку для всех автомобилистов
20.03.2026 07:32
 Местный житель пытался ограбить магазин ночью
Росгвардейцы задержали астраханца с неоплаченным алкоголем и закусками
19.03.2026 15:37
Местный житель пытался ограбить магазин ночью
Росгвардейцы задержали астраханца с неоплаченным алкоголем и закусками
19.03.2026 15:37
 Сделку предложили темные личности
Астраханец согласился перевезти 214 килограммов раков за 10 тысяч рублей
19.03.2026 14:03
Сделку предложили темные личности
Астраханец согласился перевезти 214 килограммов раков за 10 тысяч рублей
19.03.2026 14:03
 Без слез на это не взглянешь
На севере Астраханской области обнаружили свалку репчатого лука
19.03.2026 13:22
Без слез на это не взглянешь
На севере Астраханской области обнаружили свалку репчатого лука
19.03.2026 13:22
 Для профилактики деструктивных проявлений
«Я – человек»: астраханским подросткам устраивают полезные форумы
19.03.2026 12:36
Для профилактики деструктивных проявлений
«Я – человек»: астраханским подросткам устраивают полезные форумы
19.03.2026 12:36
 Защищать также будут мемориалы и места захоронения
В Астрахани обсудили защиту населения на период майских праздников
19.03.2026 11:00
Защищать также будут мемориалы и места захоронения
В Астрахани обсудили защиту населения на период майских праздников
19.03.2026 11:00
 12 лет под одним флагом
В Астрахани отметили годовщину воссоединения Крыма и Севастополя с Россией
19.03.2026 09:18
12 лет под одним флагом
В Астрахани отметили годовщину воссоединения Крыма и Севастополя с Россией
19.03.2026 09:18
 Губернатор рекомендовал выявлять риски социально-психологическим тестированием
В Астраханской области снизилось количество правонарушений с участием детей
19.03.2026 07:37
Губернатор рекомендовал выявлять риски социально-психологическим тестированием
В Астраханской области снизилось количество правонарушений с участием детей
19.03.2026 07:37
 Ветхий фасад опасно соседствует с детской площадкой
Дом в центре Астрахани проверили на аварийное состояние конструкций
18.03.2026 14:25
Ветхий фасад опасно соседствует с детской площадкой
Дом в центре Астрахани проверили на аварийное состояние конструкций
18.03.2026 14:25
 Больше поводов сходить в музей-заповедник и в театр оперы и балета
В Астрахани музей и театр получат новое современное оборудование по нацпроекту
18.03.2026 13:31
Больше поводов сходить в музей-заповедник и в театр оперы и балета
В Астрахани музей и театр получат новое современное оборудование по нацпроекту
18.03.2026 13:31
 Автомобилистам советовали спланировать маршрут заранее
В Астрахани ночью ограничат автодвижение через железнодорожный переезд
18.03.2026 12:09
Автомобилистам советовали спланировать маршрут заранее
В Астрахани ночью ограничат автодвижение через железнодорожный переезд
18.03.2026 12:09
 Есть результаты мониторинга уловов первых дней путины
Крепкий лед помешал началу путины в Астраханской области
18.03.2026 09:21
Есть результаты мониторинга уловов первых дней путины
Крепкий лед помешал началу путины в Астраханской области
18.03.2026 09:21
 Астраханский проект сформировал базу лучших родительских инициатив
Созданная в Астрахани премия «Особенное счастье» расширяет географию участников
18.03.2026 07:38
Астраханский проект сформировал базу лучших родительских инициатив
Созданная в Астрахани премия «Особенное счастье» расширяет географию участников
18.03.2026 07:38
 Сотрудники парка НТА позаботились о пенсионерке
В Астрахани разворачивали операцию по спасению бабушки, потерявшейся в автобусе
17.03.2026 15:19
Сотрудники парка НТА позаботились о пенсионерке
В Астрахани разворачивали операцию по спасению бабушки, потерявшейся в автобусе
17.03.2026 15:19
 Надеемся, что эти знания отложатся, но никогда вам не пригодятся
Астраханцам напомнили правила поведения при угрозе теракта и атаке БПЛА
17.03.2026 14:35
Надеемся, что эти знания отложатся, но никогда вам не пригодятся
Астраханцам напомнили правила поведения при угрозе теракта и атаке БПЛА
17.03.2026 14:35





























